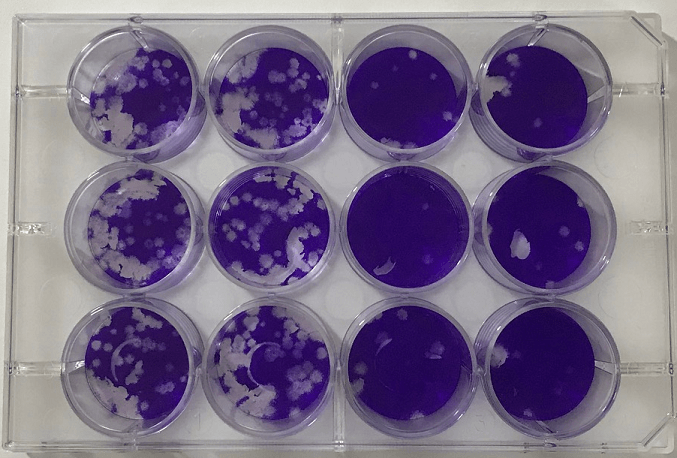

医学的に正しく、社会貢献が大きく期待される製品として、 奈良県立医科大学・MBTコンソーシアムから ロゴマークの使用が許諾。 <歯科クリニックにおける活用事例の紹介> 「ZENON 特殊アルカリ電解水/SDGs レポート(2)」を公開
株式会社ゼノン(本社:東京都中野区/代表取締役社長:阿部 昭典)は、2021年4月、公立大学法人奈良県立医科大学及び一般社団法人MBTコンソーシアムとの共同研究において、「ZENON 特殊アルカリ電解水」が、新型コロナウイルス(SARS-CoV-2)の不活効果<※>を実証したことを受け、上記団体から、医学的に正しく、社会貢献が大きく期待される製品として、MBTロゴマークの製品への使用が2022年1月許諾されました。同社では、サスティナブルな社会への貢献を目指す上で、<独自技術で生成した特殊アルカリ電解水のポテンシャル>を、共通の理念を持つMBTコンソーシアムの会員企業などに積極的に情報発信し、産官学や産産における共同開発や製品化を図り、国内外の企業や家庭における「新たなソリューション」として提供していきたいと考えています。
また、本許諾に先駆け、「ZENON 特殊アルカリ電解水」のサスティナブル性や潜在的なポテンシャルに着目し、昨年から院内の様々なシーンで活用している佐々木歯科クリニック(東京都練馬区/院長:佐々木 淳)に伺い、歯科医療現場における使用状況を取材させていただき、活用事例を「SDGs レポート(2)」としてまとめました。
[注]
- 奈良県立医科大学(理事長・学長 細井 裕司):昭和20年4月設立、橿原市
- MBTコンソーシアム(理事長 細井 裕司):医学的知識をすべての産業に投入してイノベーションを起こすMBT(Medicine-BasedTown、医学を基礎とするまちづくり)の理念を達成するために設立された一般社団法人で、現在ほぼすべての業種から170社以上が参加している。
- ウイルスの不活効果<※>:ウイルスの感染性を失わせること。
- ZENON 特殊アルカリ電解水:水と食品添加物でもある炭酸カリウムを使い、独自の生成装置を使用して生成されたアルカリ性の電解水。
- ロゴマークの許諾条件:新型コロナウイルスの不活化に関する研究実績を範囲とした許諾
(他のウイルス・細菌に関しては、他の第三者機関でエビデンスを取得しているため含みません)


歯科クリニックにおける活用事例の紹介
取材時期 :2022年2月下旬
取材場所 :佐々木歯科クリニック(東京都練馬区)
レポート方法:佐々木院長・歯科衛生士・歯科助手からのヒアリングを抜粋











導入のきっかけ
・同社の「奈良県立医科大学・MBTコンソーシアムとの共同研究/新型コロナウイルス不活化(15秒)」の配信ニュースを読み、来院する患者さんや、訪問診療時(介護施設・教育施設・ご自宅)にお会いする方々の精神的な不安を少しでも和らげたいと思い、院内外で使用を開始しました。
活用状況・理由
絶対的な安心感
・新型コロナウイルス(SARS-CoV-2)・インフルエンザ・ノロウイルス・大腸菌等への不活効果をはじめ、皮膚への安全性や水質検査などの沢山のエビデンスを、長年の販売実績と共に公開していることがきっかけでした。常に清潔を維持する責務のある私達にとっても、また身体的な接触もある患者さんにとっても、安心・安全面で他社製とは大きく異なると思いました。
水・シンプル・技術革新
・電解水自体が持っている性能や効能に関しては、院内で酸性電解水を使用した経験から多少の知識は持っていましたが、身近なモノや場所の除菌清掃用としては、先ずは下地の汚れを落とすことが必要で、その点においては、アルカリ性電解水が、アルコールや酸性電解水よりも優れていることを、メーカーの担当者からの説明で知りました。ひと昔前は、アルカリ電解水は苛性ソーダのようなモノが入っているため危険なモノと勝手にイメージしていましたが、「ZENON 特殊アルカリ電解水」は、食品添加物の炭酸カリウムだけで電解生成しているようなので、電解水の業界も日進月歩の技術革新が進んでいるんだなと感じています。
歯科現場ならではの悩み
・他の歯科医院同様に、当クリニックでも様々な歯科医療器具や用品があります。治療用のチェアユニットやワークテーブルをはじめ、待合室のイスやテーブルなど日頃の除菌清掃用としての使用の他、どうしても汚水を含めた水滴が飛び散る場所にある金属製のステンレストレーなどの用品や器具、スチールバーなどの材料の滅菌や洗浄などにも、アルカリ性の特徴である「錆の心配がない」ので使用しています。また、消毒や滅菌のために毎日使用している「オートクレーブ(高圧蒸気滅菌器)」では、熱に弱いために使用できないプラスチック製の器具や用品の一次洗浄剤として使用している他、タンパク汚れをキレイに落とすために、「超音波洗浄器」の洗浄液としても活用しています。器具の中には、アルミ製のモノもあるので、使用箇所には多少の注意が必要ですが、泡なしで二度拭きの手間がないのも、歯科衛生士・歯科助手は重宝しているようです。
家庭でのおすすめ・新習慣
・私たちの口の中には、無数の細菌が生息しています。家庭内で感染の危険のある虫歯菌や歯周病菌も、ブラッシング後の歯ブラシやコップに付着し生息します。それらは一生懸命に水道水でゆすいでも、完全に除去することは不可能です。アルカリ電解水には、血液・体液などのタンパク質の汚れや脂質等を速やかに除去(溶解)する作用がありますので、この特徴を活かして、家族間での感染予防対策として、アルカリ電解水に漬け(またはスプレー)、タンパク質や雑菌を先ずは死滅させ、水洗い後に乾燥して使用するという流れを、日常的新たな習慣にしていただくことを、私はお勧めしています。(動物の毛の歯ブラシなどを愛用している患者さんを除く)
関連ニュースリリース
当社では、2021年4月28日に下記のお知らせを公開しています。
~奈良県立医科大学との共同研究~
「新型コロナウイルスに対する不活化効果の評価」に関する研究報告
<アルカリ電解水で国内!!奈良県立医科大学との共同研究により、「ZENON 特殊アルカリ電解水」が、新型コロナウイルス(SARS-CoV-2)に対する不活化効果<15秒>を確認>!!
https://znn.co.jp/news/1805/



資料「ZENON 特殊アルカリ電解水<除菌洗浄液>」の特徴

(1) 幅広いウイルス・細菌への有効性が実証されている
アルコールでは効きにくいウイルスや、食中毒の原因菌へ除菌効果があります。詳細は当社ホームページで公表しています。(一定の条件下での検証結果。全ての菌・ウイルスに対して効果があるわけではありません)
(2) 経時変化・劣化が少ない(ロングライフ性能)
時間経過による品質劣化が問題となる次亜塩素酸水など様々な電解水(pH値が変化し洗浄や除菌効果が落ちてしまう。この傾向は、酸性・アルカリ性製品を問わずある)の中で、約6年間の性能維持を確認。計画的な在庫消費型洗浄剤として、また災害備蓄品などとしてムダにならない活用が可能です。
(3) 汚れに強く、表面残留物が少ない
汚れの内部に強力に浸透し、油汚れなどのしつこい汚れもきれいに落とします。成分は水だけで、界面活性剤・化学薬品・アルコールを一切使用していませんので、表面に有害物質が残りません。
(4) 水なのに錆びず、消臭効果があります
酸性の水はサビの原因になりますが、酸性とは対極にあるアルカリ性の水ため、金属を錆から守る効果が期待できます。また、臭いの元となるバクテリアなどを強力分解。無色・無臭で、「4大悪臭」への消臭効果も証明しています。(アルカリに反応しやすい金属(アルミニウム・真鍮・銅など)には使用できません)
(5) 様々な分野で使用されています
強力な洗浄力と、除菌・消臭効果などから、食品加工場・飲食店などの食品分野、ホテル・ビルメンテナンスなどの施設分野、切削工場などの工業分野、学校などの教育施設などの生活分野など、様々な分野で使用されています。
(6) 労働環境・環境保護にも優しい
界面活性剤や化学薬品を一切含まないため、生活空間や工場などの労働空間に残存することはありません。自然環境中に排出しても水に戻るため、環境保護にも有効と考えています。
(7) 引火性・発泡がないため扱いやすい
水のため、引火による火災リスクや輸出制限を気にすることなく使うことができます。また、一般的な洗剤で発生する「泡」がでないため、「すすぎの面倒や二度拭き」の必要がありません。

会社概要
商号 : 株式会社ゼノン
代表者 : 代表取締役社長 阿部 昭典
本社 : 〒165-0032 東京都中野区鷺宮5-6-23
(営業部:〒176-0012 東京都練馬区豊玉北4-26-6 1F)
設立 : 1989年11月(平成元年11月27日)
事業内容: 特殊アルカリ電解水の製造販売
資本金 : 1,000万円
URL : https://znn.co.jp/